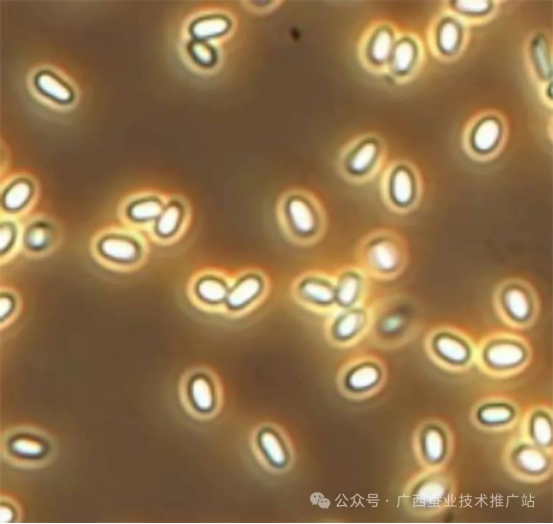

一、病原
1.家蠶微粒子病,是一種既可以食下傳染又可以胚種傳染的病害,是蠶種生產(chǎn)危害最大的蠶病。
2.家蠶微粒子病主要由家蠶微孢子蟲感染家蠶引起,一些昆蟲微孢子蟲感染家蠶也引起家蠶發(fā)生微粒子病。所有蠶種必須經(jīng)過以微孢子蟲為檢疫對(duì)象,判定檢驗(yàn)合格才能應(yīng)用于養(yǎng)蠶生產(chǎn)。家蠶微粒子病是一種慢性病,從感染到發(fā)病時(shí)間為10天以上。
3.特征
(1)家蠶微粒子病病原,呈橢圓形(下圖)
(2)具有特殊結(jié)構(gòu)極絲浸染蠶體,有堅(jiān)硬幾丁質(zhì)外殼(下圖)保護(hù)孢子

(3)孢子感染蠶體24小時(shí)中腸就形成密密麻麻的孢子裂殖體(下圖)。

二、典型癥狀
1.家蠶群體發(fā)育參差不齊、半蛻皮蠶、不蛻皮蠶,有的病蠶體表有胡椒狀斑點(diǎn)、絲腺上有白色泡狀物等。一般飼養(yǎng)感染家蠶微孢子蟲的母蛾產(chǎn)下的蠶種(即檢疫不合格蠶種),從1齡蠶開始就陸續(xù)死亡,4齡前會(huì)全部死亡;小蠶期(1齡或2齡蠶)感染家蠶微孢子蟲,5齡起蠶也會(huì)發(fā)病逐漸死亡,最后蠶體縮短吐液而死;一般受到孢子輕微胚種傳染或1-2齡蠶受到孢子感染能夠發(fā)育到5齡后期的家蠶的絲腺上才出現(xiàn)白色泡狀物,是該病重要的診斷方式。
(1)家蠶群體發(fā)育不整齊(下圖)




(2)不蛻皮蠶、起縮蠶(下圖)

(3)絲腺有白色泡狀物(下圖)

(4)大蠶期大規(guī)模發(fā)生微粒子病死亡。(下圖)

三、防控家蠶微粒子病關(guān)鍵技術(shù)
1.所有生產(chǎn)蠶種必須經(jīng)過檢疫,養(yǎng)蠶生產(chǎn)必須使用檢疫合格的蠶種。
2.養(yǎng)蠶生產(chǎn)做好養(yǎng)蠶前、后消毒工作;養(yǎng)蠶期間,做好蠶體蠶座消毒;蠶種生產(chǎn)因地制宜進(jìn)行桑園桑葉噴灑消毒或桑葉浸泡消毒(利用有效氯0.33-0.35%浸泡10分鐘,再使用清水洗滌)。
3.野外昆蟲微孢子蟲對(duì)家蠶存在交叉?zhèn)魅撅L(fēng)險(xiǎn),如菜粉蝶、桑尺蠖、桑螟、斜紋夜蛾以及稻縱卷葉螟等昆蟲都攜帶有微孢子蟲感染家蠶,必須加強(qiáng)防蟲殺蟲。
4.家蠶微粒子病可以使用阿苯達(dá)唑、多菌靈等藥物進(jìn)行有效治療。
5.家蠶微孢子蟲感染性非常強(qiáng),真正的家蠶微孢子蟲低密度孢子胚種傳染和食下感染都會(huì)造成蠶期大規(guī)模死亡,必須高度重視預(yù)防。
(esilk.net聲明:本網(wǎng)登載此文旨在傳遞更多行業(yè)資訊,文章內(nèi)容僅供參考。)

